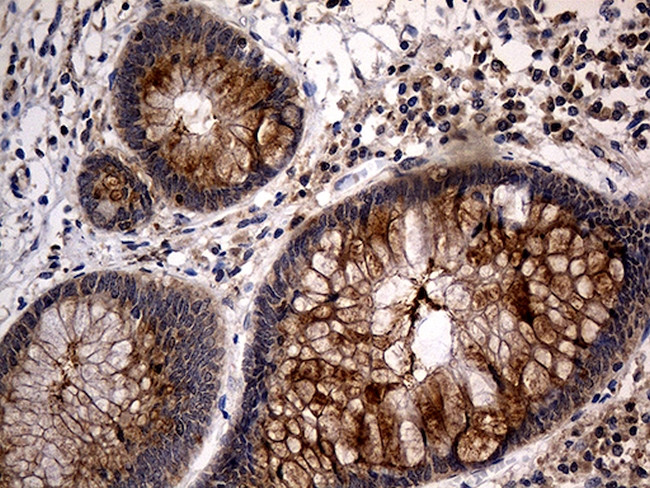
TANK Antibody in Immunohistochemistry (Paraffin) (IHC (P))

Search
OriGene
TANK Monoclonal Antibody (OTI1G2), TrueMAB™
{{$productOrderCtrl.translations['antibody.pdp.commerceCard.promotion.promotions']}}
{{$productOrderCtrl.translations['antibody.pdp.commerceCard.promotion.viewpromo']}}
{{$productOrderCtrl.translations['antibody.pdp.commerceCard.promotion.promocode']}}: {{promo.promoCode}} {{promo.promoTitle}} {{promo.promoDescription}}. {{$productOrderCtrl.translations['antibody.pdp.commerceCard.promotion.learnmore']}}







Please note: We are reviewing Western blot images included in the antibody testing data in our catalog, including those provided by third parties. Unless expressly labeled or annotated as “raw-unedited”, Western blot images included in the antibody testing data in our catalog may have been edited, optimized or otherwise adjusted for presentation.
产品信息
TA810317
种属反应
宿主/亚型
分类
类型
克隆号
抗原
偶联物
形式
浓度
规格
纯化类型
保存液
内含物
保存条件
运输条件
靶标信息
TANK was initially identified as a novel TRAF-interacting protein that regulated TRAF-mediated signal transduction. Specifically, ligand binding by surface receptors in the tumor necrosis factor (TNF) receptor and Toll/interleukin-1 (IL-1) receptor families lead to the formation of a TRAF/TANK complex that mediates the activation of the transcription factor NF-kappa-B. This activation of NF-kappa-B occurs through an association with the kinases IKK-iota and TBK1. More recently, it was shown that these proteins can then form a complex with NEMO, a protein that regulates the activity of the Ikappa-B complex. This suggests that in addition to the possibility that TBK1 and IKK-iota activate the IKKs, the association with the IKK complex may help these kinases modulate other functions, such as the transactivation potential of NF-kappa-B proteins. At least two isoforms of TANK are known to exist.
仅用于科研。不用于诊断过程。未经明确授权不得转售。
篇参考文献 (0)
生物信息学
蛋白别名: I-TRAF; OTTHUMP00000200694; OTTHUMP00000200695; OTTHUMP00000200696; OTTHUMP00000200698; OTTHUMP00000200700; OTTHUMP00000200703; OTTHUMP00000200704; TRAF family member-associated Nf-kappa B activator; TRAF family member-associated NF-kappa-B activator; TRAF interacting protein TANK; TRAF-interacting protein
基因别名: ITRAF; TANK; TRAF2
Entrez Gene ID: (Rat) 252961